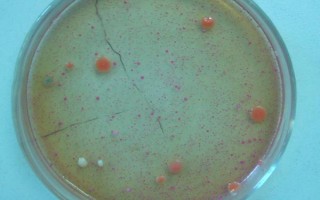
红薯秧如何做青储饲料，红薯秧一定要粉碎处理

哪些宠物狗比较便宜,一般喂食商品狗饲料
喂养原则:对于食欲不佳的狗狗,可让它饿一段时间再喂食。饲养期间,根据狗狗的品种调整饲喂次数,比如饲养香肠犬时,饲喂频率可超过4次/天,但每次要控制好喂食量,如果饲喂半干性犬料,则要减少喂食量。喂养方式...
06-22
1、准备物料:准备粉碎的红薯秧、干秸秆、玉米粉(或麦麸)、发酵剂原液。
2、稀释菌液:将发酵剂和玉米粉(或麦麸)按照1:5-10比例混匀,然后撒至粉碎的红薯秧中。
3、水分要求:混合物料含水量控制在50%左右。
4、温度要求:保持20℃以上温度,密封发酵5-10天。
5、密封要求:将混合物料装至塑料袋、缸等密封性好的容器中完全密封发酵。

1、准备物料
准备需要发酵的红薯秧(一定要粉碎),如果是新鲜的红薯秧同时还需要准备一些干秸秆、玉米粉或麦麸、发酵剂原液。

2、稀释菌液
一定要将发酵剂和玉米粉或麦麸按1:5-10 的比例混合均匀,然后再将其撒到粉碎的红薯秧中。

3、水分要求
(1)配好的物料含水量必须控制在50%左右,判断办法:手抓一把物料可以成团,指缝见水不滴水,落地即散为宜。
(2)如果物料的水分含量太大,可以加一些干物料来调节(比如干的小麦秸、玉米秆等)水分含量,如果物料含水量小,可以加水来调整。

4、温度要求
在20°C以上的温度密封发酵5-10天左右。

5、密封要求
(1)物料调整好水分后可装到塑料袋、缸等密封性好的容器中, 一定要完全密封。
(2)当使用密封性不严的容器发酵时,外面可以加套1层塑料薄膜或袋子,再用橡皮筋扎紧进行密封。

6、发酵完全
在气温比较高的情况下下密封发酵3天左右,等物料有酒香气时就说明发酵完成。

7、注意事项
(1)在发酵过程中一定不可拆开翻倒,发酵后的成品在每次取料饲喂后必须要马上密封。
(2)因为红薯藤的含水量非常高,在操作过程中可以把红薯藤先进行晾晒,或者在青贮红薯藤的过程中多加入一些干草料稀释水分。

青贮饲料发酵剂中主要有乳酸菌、产丙酸丙酸杆菌、布氏乳杆菌、副干酪乳杆菌等菌种。青贮饲料发酵主要分为3个阶段,具体如下:
1、阶段一
在此阶段中,酵母菌、霉菌、醋酸菌、腐败菌等好气性微生物,利用植物细胞挤压出的汁液迅速繁殖,导致青饲料中的蛋白质被变坏,产生大量吲哚、气体以及少许醋酸,形成厌氧环境,同时还放出热量,为后续乳酸菌发酵创造了条件。
2、阶段二
在此阶段中,乳酸菌迅速繁殖,产生大量乳酸,导致ph下降,腐败菌、酪酸菌活动受到抑制。当ph下降至4.2以下时,各种有害微生物包含乳酸链球菌活动受到抑制,只有乳酸杆菌存在。当ph为3时,乳酸杆菌同样停止活动,此时发酵基本结束。

3、阶段三
在此阶段中,青贮饲料中的各种微生物全部停止活动,只有少许乳酸菌存在,营养物质不再损失。
标签: 红薯秧如何做青储饲料
相关文章
喂养原则:对于食欲不佳的狗狗,可让它饿一段时间再喂食。饲养期间,根据狗狗的品种调整饲喂次数,比如饲养香肠犬时,饲喂频率可超过4次/天,但每次要控制好喂食量,如果饲喂半干性犬料,则要减少喂食量。喂养方式...
06-22
孔雀鱼可能会被撑死。孔雀鱼的饱腹感并不强,它们要吃撑后才会离开食物,若投喂膨化饲料,当孔雀鱼吃撑后会在其体内膨胀,此时可能会导致它们死亡。饲养期间,应该定时定量对孔雀鱼喂食,这样能让它们长得更好。白天...
02-25
捣碎仙人掌可清热解毒,治疗猪发烧和湿热引起的拉稀,100斤的猪口服半斤仙人掌汤药。可以在饲料中添加马齿苋,清热解毒,适用于夏季食欲不振、便秘和中暑的猪。益母草可有效治疗母猪不发情,产后还促进排除异物,...
06-09
鹅是素食动物,它们只吃青草、饲料、谷类作物等素食。人工养殖时,通常主喂天然的植物性饲料,比如青草,消耗量为2公斤左右/天。雏鹅破壳后,当天便可摄食青草。在条件适宜的情况下,应以放牧为主。圈养鹅,要投喂...
07-24
1、养殖场所:于水源充足、水质干净的池塘或河流周围建造养殖池,并保持环境安静,同时在池中央人工堆积小岛。2、选择龟苗:挑选身体状况良好、四肢强壮、眼睛炯炯有神的龟苗。3、投放龟苗:控制好投放密度以及雌...
08-22
2-3月龄:母乳+补料混合喂养,补料可用玉米面+玉米秸粉+麸皮+豆饼+棉籽饼+磷酸氢钙+微量元素和维生素添加剂+食盐。6月龄到体成熟:玉米面+棉籽饼+麸皮+豆饼+磷酸氢钙+微量元素和维生素添加剂+食盐...
08-23
钓获的鲫鱼可投喂蚯蚓、红虫等动物性饲料,以及玉米、小麦、大米、红薯、蔬菜嫩叶等植物性食物。由于鱼钩拉扯,鲫鱼嘴巴很容易出现受伤的情况,还会影响进食,所以并不容易饲养。如果嘴巴受伤的情况不严重可以把它们...
07-14
根据宠粮的外观挑选:主要从颗粒表面是否光滑、颗粒颜色、饲料含油量等进行挑选。根据气味和口感挑选:根据宠粮的气味、质地、口感等进行挑选。宠粮泡水实验:宠粮泡水后,根据软化程度、膨胀程度、水透明度等进行挑...
06-27
饲料鸡2个月左右即可出栏,杂交土鸡需4个月左右出栏,纯土鸡则要5个月左右。当肉鸡达到6-7周龄、体重达到1.9-2公斤时即达到出栏标准,出栏时要充分考虑饲料消耗、屠体品质、市场需求等因素。饲料鸡的养殖...
06-02
生长速度比较快的牛种有夏洛莱牛、西门塔尔牛、三元杂交牛、利木赞牛等。夏洛莱牛:头小且宽,角圆且长,颈粗短,胸宽深,背宽肉厚,体躯呈圆筒状,肌肉丰满,后臀肌肉发达。成年公牛平均体重1.1-1.2吨,母牛...
05-23
热点文章
富尔5152玉米栽培技术要点,种植密度每亩5500株
不锈钢锅能不能长期放醋,不可长期盛放
凤尾竹冬季如何浇水,凤尾竹不耐严寒怕冻
扬麦21小麦栽培技术要点,该品种表现幼苗直立
L2318玉米栽培技术要点,适宜播种期4月下旬至5月上旬
工厂化生产番茄每平方米面积的产量,一般可以超过30公斤
吉育654大豆栽培技术要点,高抗大豆灰斑病
碗莲入泥定植的方法,将种子播入花土中再浇水淹没